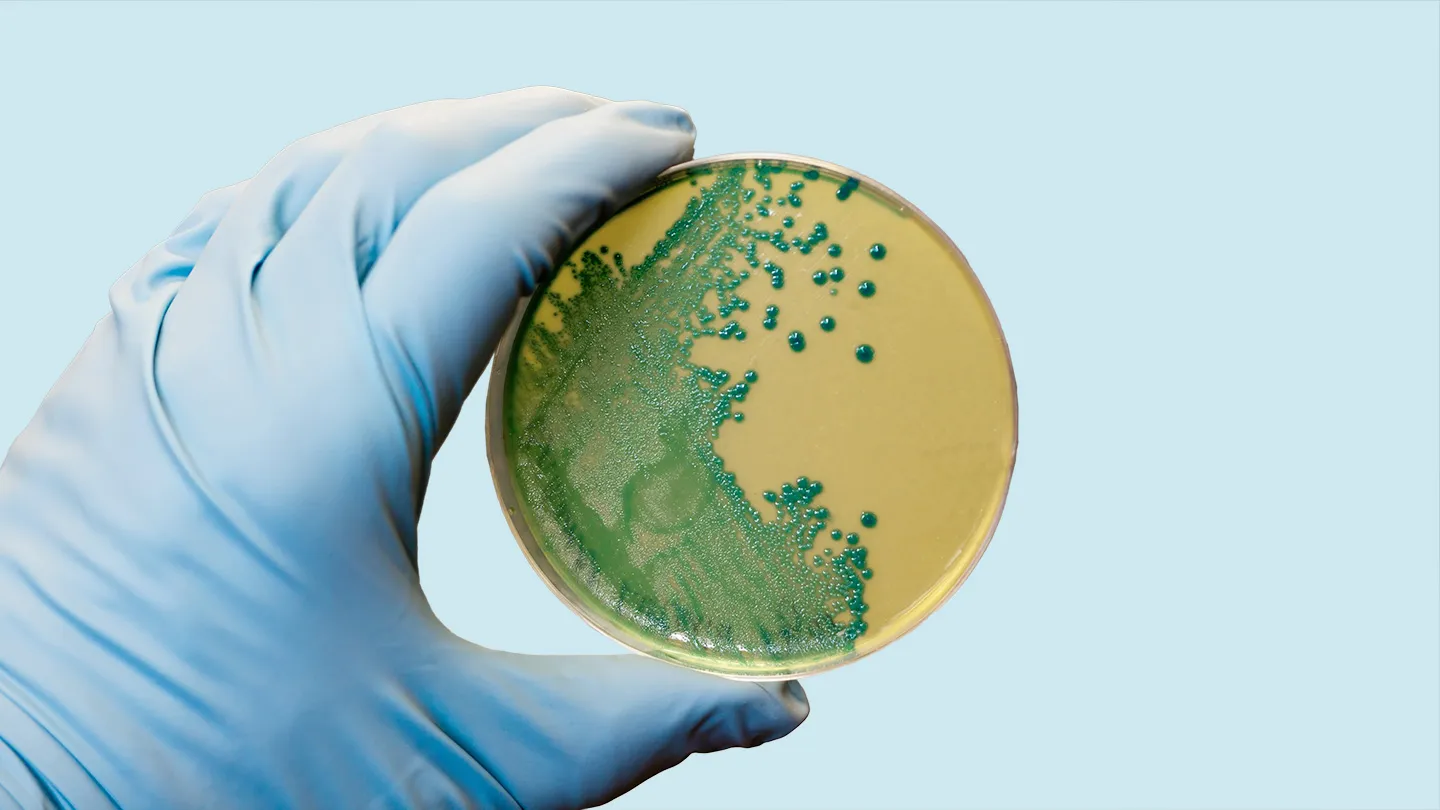
ABD’de hazır makarnadan listeria alarmı: 6 kişi öldü 2 listeria

ABD’de hazır makarnadan listeria alarmı: 6 kişi öldü
ABD’de önceden pişirilmiş makarna yemeklerinde tespit edilen Listeria bakterisi nedeniyle 6 kişi yaşamını yitirdi, 25 kişi hastaneye kaldırıldı. Trader Joe’s, Walmart ve Kroger gibi zincirlerde satılan ürünler acilen geri çağrıldı.
ABD Gıda ve İlaç Dairesi (FDA), ülkede yaygın satışta olan hazır makarna yemekleriyle bağlantılı Listeria salgını nedeniyle ölü sayısının 6’ya yükseldiğini açıkladı. Haziran ayında duyurulan salgın sonrası, tedarikçi firma Nate’s Fine Foods ürünlerini içeren çok sayıda hazır yemek markası geri çağrıldı. FDA, Hastalık Kontrol ve Önleme Merkezi (CDC) ile birlikte çok eyaletli bu salgını araştırıyor. Kurumun güncellemesine göre, 27 kişi hastalandı, 25’i hastanede tedavi altına alındı.
18 eyalette listeria vakası tespit edildi
Salgın şu ana kadar California, Florida, Illinois, Michigan, North Carolina, Texas ve Washington dahil olmak üzere 18 eyalette görüldü. FDA, halkı evdeki buzdolabı ve dondurucularını kontrol etmeleri konusunda uyardı.
Geri çağrılan markalar ve ürünler
Recalled (geri çağrılan) ürünler arasında şu markalar yer alıyor:
FreshRealm Home Chef Chicken Fettuccine Alfredo (Kroger, Walmart)
Marketside Grilled Chicken Alfredo with Fettuccine (Kroger, Walmart)
Marketside Linguine with Beef Meatballs & Marinara Sauce (Walmart)
Trader Joe’s Cajun Style Chicken Fettuccine Alfredo
Albertsons, Safeway, Vons markalı makarna salataları
Scott & Jon’s Shrimp Scampi with Linguini Bowls
Kroger ve Giant Eagle makarna salataları
Sprouts Farmers Market Smoked Mozzarella Pasta Salad
FDA, tüketicilerin bu ürünleri derhal imha etmeleri veya satın aldıkları mağazalara iade etmeleri çağrısında bulundu.




